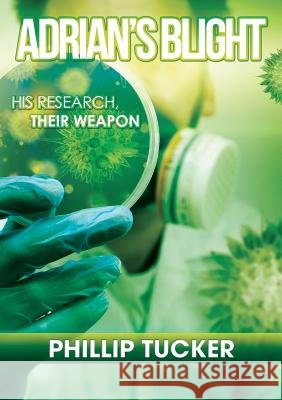
Adrian's Blight Phillip J Tucker   9780994321756

Wyniki wyszukiwania:
wyszukanych pozycji: 48
 |
Miller Cornfield at Antietam: The Civil War's Bloodiest Combat
ISBN: 9781625858658 / Angielski / Miękka / 2017 / 256 str. Termin realizacji zamówienia: ok. 16-18 dni roboczych. On September 17, 1862, the forces of Major General George B. McClellan and his Union Army of the Potomac confronted Robert E. Lee's entire Army of Northern Virginia at the Battle of Antietam in Sharpsburg, Maryland. The Union forces mounted a powerful assault on Lee's left flank in the idyllic Miller Cornfield. It was the single bloodiest day in the history of the Civil War. The elite combat units of the Union's Iron Brigade and the Confederate Texas Brigade held a dramatic showdown and suffered immense losses through vicious attacks and counterattacks sweeping through the cornstalks. Author...
On September 17, 1862, the forces of Major General George B. McClellan and his Union Army of the Potomac confronted Robert E. Lee's entire Army of Nor...
|
cena:
99,97 |
 |
The Irish at Gettysburg
ISBN: 9781467138529 / Angielski / Miękka / 2018 / 240 str. Termin realizacji zamówienia: ok. 16-18 dni roboczych. |
cena:
99,97 |
 |
Forgotten Stonewall of the West
ISBN: 9780865545304 / Angielski / Twarda / 1997 / 400 str. Termin realizacji zamówienia: ok. 16-18 dni roboczych. Parallels the lives of Bowen and Grant, and argues that Bowen was one of the best commanders of the Confederacy. For Civil War buffs. Annotation c. by Book News, Inc., Portland, Or.
Parallels the lives of Bowen and Grant, and argues that Bowen was one of the best commanders of the Confederacy. For Civil War buffs. Annotation c. by...
|
cena:
196,86 |
 |
The Path To Betrayal
ISBN: 9780994321701 / Angielski / Miękka / 2015 / 410 str. Termin realizacji zamówienia: ok. 16-18 dni roboczych. Can a small group of men change history? Since the dawn of modern warfare, small groups of trained soldiers equipped with the right equipment, and more importantly 'Intelligence' have carried out missions that have led to major victories and crushing defeats. This is the story of one of those units. Steve Roberts is a young man with the same aims and hopes of many young men just starting out in life. His gift is that he's a good soldier, who excels at his profession. Approached by the Americans to join a special unit, to help counter their enemies around the world, Steve enters a world where...
Can a small group of men change history? Since the dawn of modern warfare, small groups of trained soldiers equipped with the right equipment, and mor...
|
cena:
76,01 |
 |
The Path to Vengeance
ISBN: 9780994323125 / Angielski / Miękka / 2017 / 308 str. Termin realizacji zamówienia: ok. 16-18 dni roboczych. |
cena:
60,01 |
 |
Coby's Search
ISBN: 9780994323149 / Angielski / Miękka / 2017 / 302 str. Termin realizacji zamówienia: ok. 16-18 dni roboczych. |
cena:
56,09 |
 |
The Path To Redemption
ISBN: 9780994321718 / Angielski / Miękka / 2015 / 300 str. Termin realizacji zamówienia: ok. 16-18 dni roboczych. When a pardon isn't a pardon After being on the run from the CIA and Mossad for nearly twenty years, Ali's special opts unit is pardoned by the American President. Steve Robert's, one of the unit members has his doubts. As he starts his journey home to Australia and hopefully peace, he discovers that his girlfriend has been brutally murdered. Broken by the news, Steve sadly contemplates, if it is just an incredible coincidence, or has his unit again been betrayed and targeted. Paralysed by the unknown, Steve battles to make a decision. Should he carry on and go home, or should he warn the...
When a pardon isn't a pardon After being on the run from the CIA and Mossad for nearly twenty years, Ali's special opts unit is pardoned by the Ameri...
|
cena:
60,01 |
|
Adrian's Blight
ISBN: 9780994321756 / Angielski / Miękka / 2015 / 230 str. Termin realizacji zamówienia: ok. 16-18 dni roboczych. His research, their weapon A young man dreams of honouring his father's memory, by changing the World. Having been invited to attend a prestigious think tank University in America, Adrian thinks his wish has come true. While carrying out his revolutionary experiments on DNA weed eradication, Adrian comes face to face with the illusionary truth. What is his research really being used for? And has he been deceived like his father before him? With the worlds most dangerous men hunting him, Adrian must decide what to do about his research and his supposed allies.
His research, their weapon A young man dreams of honouring his father's memory, by changing the World. Having been invited to attend a prestigious thi...
|
cena:
48,01 |
Silenced Revelation About An Icon: Suicide of the Alamo’s Commander, William Barret Travis
ISBN: 9781794876965 / Angielski / Miękka / 2020 / 238 str. Termin realizacji zamówienia: ok. 16-18 dni roboczych. |
|
cena:
80,56 |
 |
Nat Turner's Holy War To Destroy Slavery
ISBN: 9781365588549 / Angielski / Miękka / 2017 / 198 str. Termin realizacji zamówienia: ok. 16-18 dni roboczych. |
cena:
67,17 |
 |
Ranger Raid: The Legendary Robert Rogers and His Most Famous Frontier Battle
ISBN: 9780811739733 / Angielski / Twarda / 2021 / 552 str. Termin realizacji zamówienia: ok. 16-18 dni roboczych. |
cena:
139,82 |
 |
A New Look at the Buffalo Soldier Experience in Wartime
ISBN: 9781387766444 / Angielski / Miękka / 2018 / 272 str. Termin realizacji zamówienia: ok. 16-18 dni roboczych. |
cena:
76,08 |
 |
Forgotten Contributions of Little Africa Soldiers at Fort Wagner
ISBN: 9780359241866 / Angielski / Miękka / 2018 / 232 str. Termin realizacji zamówienia: ok. 16-18 dni roboczych. |
cena:
76,08 |
 |
Storming Little Round Top: The 15th Alabama and Their Fight for the High Ground, July 2, 1863
ISBN: 9780306811463 / Angielski / Twarda / 2002 / 344 str. Termin realizacji zamówienia: ok. 16-18 dni roboczych. The fight for Little Round Top on July 2, 1863, is forever etched in the annals of America's Civil War. The heroic defense of the high ground by Joshua Chamberlain and the men of the 20th Maine is one of the most famous incidents in American history, made more so by its powerful depiction in the film Gettysburg. There are numerous written accounts of the Union defenders on Little Round Top but considerably less has been written--up to now--about the Confederate attackers who charged up the hill and faced an even more desperate challenge than those who defended it. Unique and colorful,...
The fight for Little Round Top on July 2, 1863, is forever etched in the annals of America's Civil War. The heroic defense of the high ground by Joshu...
|
cena:
156,02 |
 |
Custer's Lost Official Report of the Battle of Gettysburg July 3, 1863
ISBN: 9780359553204 / Angielski / Miękka / 2019 / 38 str. Termin realizacji zamówienia: ok. 16-18 dni roboczych. |
cena:
44,76 |
Why Custer Was Never Warned: The Forgotten Story of the True Genesis of America's Most Iconic Military Disaster, Custer's Last Stand
ISBN: 9781627341868 / Angielski / Twarda / 2017 / 242 str. Termin realizacji zamówienia: ok. 16-18 dni roboczych. |
|
cena:
205,88 |
 |
Irish Confederates: The Civil War's Forgotten Soldiers
ISBN: 9781893114531 / Angielski / Miękka / 2007 / 127 str. Termin realizacji zamówienia: ok. 16-18 dni roboczych. Contemporary Civil War scholarship has brought to light the important roles certain ethnic groups played during that tumultuous time in our nation's history. The axiom that the winners of wars write the histories is especially valid in regard to the story of the Irish who fought for the Confederacy from 1861-1865. Throughout the course of the Civil War, Irish Confederates made invaluable contributions to all aspects of the war effort. Yet, the Irish have largely been the forgotten soldiers of the South. In Irish Confederates: The Civil War's Forgotten Soldiers, author Phillip T. Tucker...
Contemporary Civil War scholarship has brought to light the important roles certain ethnic groups played during that tumultuous time in our nation's h...
|
cena:
67,81 |
 |
Be Free Or Die!: Harriett Tubman In Her Own Words
ISBN: 9780359872268 / Angielski / Miękka / 2019 / 104 str. Termin realizacji zamówienia: ok. 16-18 dni roboczych. |
cena:
44,76 |
 |
For Honor, Country, and God: Los Niños Héroes
ISBN: 9781387349715 / Angielski / Miękka / 2017 / 240 str. Termin realizacji zamówienia: ok. 16-18 dni roboczych. |
cena:
71,64 |
 |
The Important Role of the Irish in the American Revolution
ISBN: 9780788450181 / Angielski / Miękka / 2013 / 142 str. Termin realizacji zamówienia: ok. 16-18 dni roboczych. The important roles and contributions of the Irish in the struggle for American Independence has been minimized and overlooked by historians, both American and Irish, for generations. Quite simply, American Independence could not have been won without the vital, widespread, and timely contributions-military, political, and economic-of the Irish from 1775 to 1783. To demonstrate the widespread extent of the Irish contribution and its importance in winning final victory, this work has focused on the long-overlooked achievements of the Irish in such important battles as Trenton, Kings Mountain,...
The important roles and contributions of the Irish in the struggle for American Independence has been minimized and overlooked by historians, both Ame...
|
cena:
87,37 |











